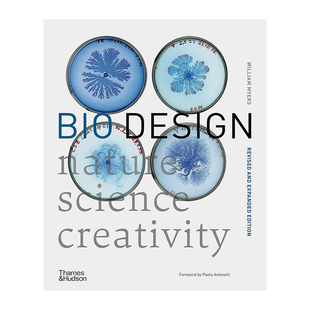
【现货】 Bio Design (New ed) /anglais 自然生物设计:自然·科学·创造力 生物科技艺术设计运用 英文书 正版 ANTONELLI WILLIAM

【预售】气候危机中的跨领域前景anglais 再行动中的建筑研究Transcalar Prospects in Climate Crisis /anglais英文建筑设计城市


【法文版】小企鹅乔比识字书 英法对照 MON IMAGIER TCHOUPI FRANCAIS ANGLAIS 法文原版 法语初学者【中商原版】


【预售】月宫(英格兰联赛 2024-2025) Moon palace (llcer anglais 2024-2025) 英文进口原版文学传记正版图书籍Paul Auster


【预售】丹尼尔·施瓦茨:足迹 Daniel Schwartz Tracings /anglais 原版英文摄影作品集图书


【预售】泰勒韦辛人像摄影奖2025 Taylor Wessing Photo Portrait Prize 2025 /anglais 原版英文摄影作品集图书


【预售】芙洛拉·尤赫诺维奇 Flora Yukhnovich /anglais 原版英文艺术画册画集图书


【预售】气候危机中的跨领域前景/anglais: 再行动中的建筑研究 Transcalar Prospects ...英文进口原版城市规划设计图书 Jeffr


【预售】泰特美术馆摄影莉兹·约翰逊-阿图尔/英语 Tate Photography Liz Johnson-Artur /anglais 进口书籍 摄影书籍


【现货】 John Galliano Unseen /anglais 约翰·加利亚诺:无形 英文版 艺术 服饰 时尚服装设计 英文原版图书籍正版 FAIRER ROBE


1h可退 香港直邮Simkhai 女士 Nicolette Anglais 刺绣连身连体泳


1h可退 香港直邮Simkhai 女士 Nicolette Anglais 刺绣连身连体泳


1h可退 香港直邮Simkhai 女士 Nicolette Anglais 刺绣连身连体泳


1h可退 香港直邮潮奢 Simkhai 女士 Nicolette Anglais 刺绣连身


1h可退 潮奢 Simkhai 女士 Nicolette Anglais 刺绣连身连体泳衣


【现货】英文原版Henri Cartier-Bresson The Other Coronation /anglais亨利·卡地亚·布列松 另一次加冕 摄影艺术书籍


【预售】气候危机中的跨领域前景anglais 再行动中的建筑研究Transcalar Prospects in Climate Crisis /anglais英文建筑设计城市


【现货】威尔汉姆·哈默修伊 Vilhelm Hammershoi /anglais


日本直邮TOMMY HILFIGER Broadley Anglais 女装A字裙半身裙


【现货】 Stephen Shore Solving Pictures /anglais 斯蒂芬·肖尔:破译照片 英文原版图书正版 艺术摄影作品集 BAJAC QUENTIN CA


KENZO 女士半身裙 FE52RO2599K102 SS2024 白色 Broderie Anglais


【现货】Chanel Catwalk: The Complete Collections (2nd ed) /anglais 香奈儿 T台秀 卡尔拉格斐 时尚服饰服装设计作品集原版


【现货】 Alexander McQueen Unseen /anglais 亚历山大·麦昆:无形 英文版 服装服饰时尚时装 英文原版图书籍正版 FAIRER ROBERT


【现货】 普拉达 T台秀 完全收藏 Prada Catwalk The Complete Collections /anglais 英文原版图书籍进口正版 FRANKEL SUSANNAH


【现货】 Chanel: The Karl Lagerfeld Campaigns /anglais 香奈儿:卡尔.拉格斐风潮 服装时尚设计 英文原版正版 MAURIES PATRICK


【现货】 Japanese Design Since 1945: A Complete Sourcebook /anglais 现代日本设计 日式生活与设计 英文原版图书籍正版


【预售】Alex Webb The Suffering of Light /anglais 光的痛苦 Alex Webb 阿历克斯韦伯 英文原版图书籍进口正版 摄影集艺术


【预售】 Comet: Photographs from the Rosetta Space Probe /anglais 彗星:来自罗塞塔太空探测器的照片 英文原版正版 摄影集Je


日本直邮TOMMY HILFIGER Broadley Anglais牛仔半身裙女装长款


【现货】 Shop Cats of Hong Kong /anglais 香港铺头猫 英文原版进口正版 Marcel Heijnen 喵星人 店铺招财猫咪 摄影集 作品


【现货】 JOHN & YOKO PLASTIC ONO BAND /ANGLAIS 约翰.列侬与小野洋子 塑胶小野乐队 ONO YOKO 英文原版图书籍进口 LENNON JOHN


【现货】Model City Pyongyang /anglais 模范城市平壤 北朝摄影集 英文版 英文原版图书籍进口正版 BIANCHI CRISTIANO

【现货】 Bio Design (New ed) /anglais 自然生物设计:自然·科学·创造力 生物科技艺术设计运用 英文书 正版 ANTONELLI WILLIAM


【现货】How to Raise a Loaf /anglais 如何做面包:爱上酵母面包 烘焙英文原版图书籍进口正版 Allen Roly


【现货】Forever /anglais 永远 意大利插畫師Beatrice Alemagna 英文原版图书籍进口正版 艺术绘本


【预售】丹尼尔·施瓦茨:足迹 Daniel Schwartz Tracings /anglais 原版英文摄影作品集


【预售】泰勒韦辛人像摄影奖2025 Taylor Wessing Photo Portrait Prize 2025 /anglais 原版英文摄影作品集进口书籍图书外版正版


【现货】Bauhaus Ballet /ANGLAIS 包豪斯芭蕾 英文原版图书籍进口正版 立体书 儿童童书艺术启蒙 Gabby Dawnay


【现货】La louve et l’Anglais,狼和英国人 法文儿童绘本


【现货】 The Book of Durrow /anglais 德罗之书 Insular art中世纪福音书 英文原版图书籍进口正版 TRINITY COLLEGE DUBL


【现货】 SAPIENS A GRAPHIC HISTORY /ANGLAIS (JONATHAN CAPE) 人类简史图像小说版 卷1 漫画 英文书正版 HARARI YUVAL NOAH

